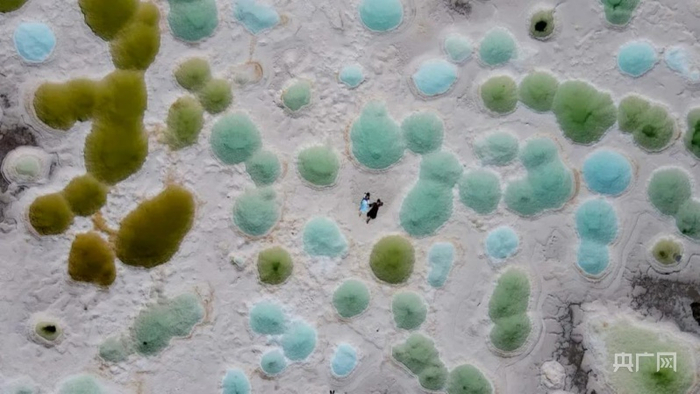
色彩斑斓的“蓝洞”（央广网 唐拓华摄）

原标题:乘着火车游“中国最孤独的城市”——茫崖
央广网西宁10月18日消息 青海省海西蒙古族藏族自治州茫崖市,被游客称为中国最孤独的城市,位于四大无人区中间节点,藏着国内少有的独特美景。
经茫崖市积极争取,中国铁路青藏集团有限公司秉持为民服务宗旨,充分考虑茫崖地区群众出行和游客通行需要,努力克服运行困难,于2021年10月11日起加密格库铁路青海段旅客列车,实现了茫崖至格尔木列车每日通行。

雄伟的昆仑山 (央广网发 唐拓华摄)
从格尔木盐湖城到茫崖石油城,这是一趟开往最孤独城市的列车,沿途分布着诸多景点,穿过草原、戈壁、沙漠、雅丹……苍茫万顷连,随时带你体会最刻骨铭心的孤独和直击心灵的震撼。
购买一张通往“瀚海星空、秘境茫崖”的车票,从格尔木市出发,列车沿着柴达木盆地昆仑山北缘并行,巍巍大山首先步入眼帘,这是万山之祖,有众多神话传说和文化故事。列车沿着丝绸古道的方向前行,辽阔的戈壁望不到边,云彩里悬挂着昆仑山,胸襟坦荡豪迈。
列车经过乌图美仁草原来到大戈壁的甘森站,甘森,蒙古语意思是苦水,前方飞鸟不见踪影,地上难找一棵树。在这荒原深处有一个神奇的宝石滩,地表散落着玛瑙、玉髓、泥石、蛋白、托帕水晶等宝玉石,独一无二的玉料尽显旭日阳刚、阴柔含蓄、风凌沧桑之美。

茫崖市花土沟站 (央广网发 唐拓华摄)
茫崖,蒙古语意为“额头”,315国道老茫崖段一处雅丹地貌为“额头”的传说。黄风山距此不远,垄槽相间的长土丘环绕地下雅丹风蚀林,经常风沙狂起、大漠飞烟,为自然环境最恶劣的区域。因风力作用,从卫星地图上像一个长约40余公里、宽约15公里的“大耳朵”轮廓,对苍茫之崖的描述更加惟妙惟肖。
列车进入老茫崖工区,往北的干盐滩在风沙作用下,吹出了一条条细密的圆规型“风道”,称为“土星环”。环半径长几公里不等,轻盈的鸟翅状沙丘如同星云分布。“土星环”组成了天然的圆周率π=3.14……,为科普研学的理想场地。无人机视角下,像圆型光盘或碟片,犹如风沙在星辰瀚海播放着大自然的声乐,穿越最不像地球的地方、最像火星的地貌!
双石峡,因两山高耸对峙而得名,远远望去像一座石门城墙,形成了一夫当关的险峻气势。石门里外花草铺成了地毯,为野生动物温馨的家园,好似昆仑西王母的石园林。

昆仑山下,水草丰美。(央广网发 唐拓华摄)
从格库铁路远观是“翡”近看有“翠”。水是眼波横,山是眉峰聚,犹如古意昂然的“青铜镜”,照着游客曼妙的身姿,与影子对话,陶醉在临水照花的婉约诗意中。茫崖翡翠湖面积达26多平方公里,属硫酸镁亚型盐湖,卤水的颜色纯美剔透,呈青翠浓淡相宜的色彩,为丝路上一幅水墨丹青的寻梦画卷。

风蚀雅丹地貌群 (央广网 唐拓华摄)
在尕斯湖东部平整的大盐滩上,分布着成百上千大小不一的自然蓝洞盐泉,如同白玉圈子镶嵌的宝石——天青色、深蓝色、白色、黄色、褐红色等色彩斑斓,形成了一幅幅奇妙无比的“盐画”。相对阿拉尔草原的“红眼睛”艾肯泉,这是代尔森草原的“蓝眼睛”,巍峨昆仑山下,盐泉宝镜闪烁着宝蓝的天、流淌的云、星月银河。
色彩斑斓的“蓝洞”(央广网 唐拓华摄)
尕斯库勒湖简称尕斯湖,蒙古语“尕斯诺尔”,意为“白玉圈子”“镶着银边的湖”。为封闭内流盆地,面积约140平方公里,是固液相并存的特大型石盐盐湖矿床。尕斯湖为石油文化之湖,柴达木文学的起源地之一。

风蚀雅丹地貌 (央广网 唐拓华摄)
位于花土沟镇东北的游园沟,大片丹霞崖貌在雨侵、风蚀作用下形成了“千佛齐聚”的场面。陡峭的红砂岩上一尊尊栩栩如生、仪态纷呈的泥塑,小的几米大的数十米,磨肩接蹱站立,千佛汇聚的壮阔画面一览无遗。
从花土沟火车站下车,进入尕斯湖畔的阿拉尔草原,会偶遇一份自然的甘醴——艾肯泉,蒙古语称之“艾肯布拉格”,意为“源头泉”。艾肯泉是茫崖额头下的大眼睛,与蓝洞一样明眸善睐,眼睑、虹膜、瞳孔泾渭分明,乃形神兼备的“大地之眼”。

艾肯泉 (央广网 唐拓华摄)
在大美青海行走,在秘境茫崖停留,坐上列车踏上最孤独的旅程,体验如梦如画穿越星际的感觉。这片柴达木盆地最西北部的“天涯海角”,吸引越来越多的游客开启生态研学之旅。(记者张海东 通讯员唐拓华)


